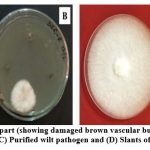
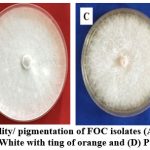

Introduction
Pulses are crucial crops of Indian agriculture as they are rich in protein and maintain the cropping systems by sustainable production.1 Chickpea is a high value pulse crop, commonly known as Gram or Chana (Cicer aritinum), and is a member of the Leguminaceae subfamily and only domesticated species of Cicer spp.2 Due to great nutritional value, chickpea is an excellent addition to the cereal diet in impoverished nations. This crop is commonly cultivated for its highly proteinated edible seeds, although it can also be produced as fodder.3
Chickpea crop is prone to biotic factors, which leads to its low yield.4 Numerous viral, bacterial, fungal, and nematode diseases can infect chickpea pulse crop.1 F. oxysporum is one of the most economically significant species in the Fusarium genus, cause Fusarium wilt (chickpea wilt), which significantly reduces chickpea production worldwide.5 Every year due to fusarium wilt epidemics, chickpea production is significantly reduced around 10 to 15% of the entire yield and can occasionally reach 100% under disease favourable circumstances.6,7 Chickpea wilt has been recorded from at least 33 nations including India from chickpea growing regions worldwide.8
Fusarium Oxysporum is classified as asexually reproducing fungi (an anamorphic species) species that lack sexual structures and recognised by morphological characteristics that’s sustain by both pathogenic and non-pathogenic strains.9 Morphological characteristics play an important role in culture identification. Mostly microbial populations observed as small, distinct morphological colonies on solid surfaces, different characteristics that underlie macroscopic microbial colonies include surface appendages, pigmentation, and cellular shape of colony. However, some of these characteristics are species-specific. Notably, numerous of these microscopic colony characteristics play a role in pathogenesis and virulence.10
Fusarium Oxysporum form thin to profuse aerial mycelium, which is white, pink, salmon and purple coloured on the back of the colony in culture. Microconidia, macroconidia and chlamydospores are the three different forms of asexual spore formed by Fusarium Oxysporum. When the host is absent, the fusarium wilt pathogen can persist in the soil for long periods of time, primarily as a thick-walled resting spore called chlamydospores.9 These spores are resistant to adverse environmental conditions like extreme temperature, chemicals and dehydration, which makes this fungus very persistent in the soil. Indeed, once an area becomes infected with F. oxysporum, it usually remains so forever.11
Based on their pathogenicity toward a specific host or set of hosts F. oxysporum strains have been classified as formae speciales. The capacity of F. oxysporum strains to parasitize plant roots, typically without causing symptoms, is a common trait. This capacity is general, and pathogenic strains can penetrate plant roots where they won’t spread illness.9
Fusarium wilt severely hampered crop’s productivity by the illness.12 Chickpea crops are prone to the wilt disease in every stage of plant growth. Sudden wilting of leaves and petioles, internal black discoloration involving xylem and pith, and no visible root rotting are characteristic symptoms of wilt disease.13 Vascular wilt and yellowing are two leading conditions that express the disease and can be identified based on their symptoms and order of beginning. The wilt disease causes fast droopiness and withering of the leaves and stems by 20 days subsequent to inoculation, however yellowing pattern causes advanced foliar, yellowing followed by necrosis 30–40 days after inoculation.14
Gerhardson emphasizes the requirement to develop the strains that are exceptionally pathogenic and unaffected to fungicides, leading to the emergence of more destructive and infectious strains, to stop the substantial use of fungicides to enhance crop yield.15
Production of resistant cultivars has been the foremost method of controlling fusarium wilt disease in different management strategies. The durability of resistant cultivars is hampered by the significant pathogenic diversity in populations of F. oxysporum f. sp. ciceri. Wilt pathogen has been divided into two pathotypes and eight races. Quick and precise identification of pathogenic races of F. oxysporum f. sp. ciceri is therefore extremely important given the reliance on resistant cultivars for the disease control of fusarium wilt.2
Wilt pathogen F. oxysporum f. sp. ciceri is quite diverse in nature. Six of the eight races of this pathogen (1A, 2, 3, 4, 5 and 6) that have been identified exhibit wilting symptoms.16 In India, there are four FOC races (1A, 2, 3, and 4) are common; race 1A is the most destructive one among these.
Fusarium wilt disease in Bundelkhand region is noticed almost every year and causes great loss to the crop. Bundelkhand region is a central part of India, which is a semiarid region. Weather conditions of this region are favourable for the cultivation of pulses 17 especially chickpea so this location was chosen for Fusarium wilt research. Local as well as identified varieties of chickpea grown in these regions have shown symptoms and none of the variety free from infection. Due to scarcity of water in Rabi season farmers are bound to cultivate chickpea every year and suffer badly from this pathogen.
The disease is soil transmitted, it is challenging to manage the disease through crop rotation or fungicide application. Practice of wilt resistant chickpea cultivars is potentially the most efficient and biological way to combat the ailment.7 The considerable pathogenic heterogeneity in the FOC, however, might reduce the efficacy of resistance.18–20 Many chickpea lines from other nations have been reported to be wilt-resistant 21, but their effectiveness has been highly contained to local areas because of race-specific strains of the disease.22 Knowledge of precise isolation to utilise for screening purposes, as well as how the resistance is established and inherited is crucial.23
In view of the above facts, the present study was aimed to conduct a comprehensive investigation on the phenotypic (cultural, morphological) variation and pathogenic variability of FOC isolates of two districts of Bundelkhand region (Uttar Pradesh). Which may help significantly to learn more about the resistance, traits, disease incidence on the natural field and pathogenicity of the wilt pathogen.
Materials and Methods
Survey/ sample collection
In present study, two districts of Bundelkhand region, (three villages from each) named Jhansi (Hastinapur, Simardha and Babina) and Lalitpur (Talbehat, Jhawar and Pooravirdha) were selected as study area during the Rabi season (December, 2017 to January 2018). Diseased chickpea plants were collected from each village (around three to five fields) of both districts (Fig. 1). This research work was carried out at IGFRI Jhansi U.P. and Department of Microbiology, Bundelkhand University, Jhansi.
![]() |
Figure 1: Chickpea field of study area (A) and (B); collected diseased plant sample (C) and (D) |
Isolation of wilt pathogen
Isolation of wilt pathogen i.e. Fusarium Oxysporum f. sp. ciceri, (FOC) was done from infected root and lower part of the stem of diseased chickpea plant samples. To isolate wilt pathogen from newly infected plant tissue, sticky soil of plant root or stem was rinsed from the samples with tap water, followed by a distilled water and three to four minutes of drying on sterilized absorbent paper.9 After that diseased part of the plant was cut in minor (2-5mm) parts. Further surface sterilization of these minor parts was done. For surface sterilization the diseased part of the plant was put in 1% NaOCl (Sodium hypochlorite solution) for 60 to 80 seconds and then afterward washed (three to four time) a way in distilled water by placing the sample for 60 sec. These sterilized diseased samples are placed aseptically on petri plates containing Potato Dextrose Agar (PDA) media. After inoculation these petri plates were incubated for 6-7 days at 260C±1 (Fig. 2).
Speculative FOC colony further purified by single spore isolation method for their identification and to obtain pure culture of Fusarium Oxysporum f. sp. ciceri, further these purified cultures were maintained on PDA petri plates and transferred on PDA slants by the periodical transfer at 260± 10C for seven days and then stored in a refrigerator at 50C (Fig. 2). These PDA slants were revived once in 30 days.24,25
![]() |
Figure 2: (A) Diseased plant part (showing damaged brown vascular bundle); (B) Isolation of wilt pathogen on PDA plate; (C) Purified wilt pathogen and (D) Slants of Purified wilt pathogen |
Phenotypic (Morphological and cultural) variability of wilt pathogen
Isolates of wilt pathogen were primarily identified by observing colony characteristics.26 To study phenotypic variability, purified FOC isolates were further categorised on pigmentation basis and studied for microscopic characteristics like colony (shape, texture and margin etc.) and spore morphology (type, size, shape etc.). Selected FOC isolates were further sub cultured and incubated for seven days, after seven days inoculation period selected FOC isolates were further studied for morphological variability.
Selected FOC isolates were observed and studied for morphological characteristics under stereoscopic (Model: Olympus) and compound microscope (Model: Olympus).23 According to Cunnington (2007), different morphological features can help to describe Fusarium Oxysporum to some extent.2 In present study under Microscope (LEICA DM 2500 LED) different spore of the FOC isolates (at 40 X magnification) were observed and measured (at 50 μm scale) by Vikram and Gangwar, 2017.1 All the isolates were tested in a single test.27 Mean value of spores size (L x B) was calculated, as well as minimum and maximum size of spores also observed:
Microconidia: For precise identification of microconidia, size, form, etc. examined under compound microscope.
Macroconidia: For exact identification of macroconidia, number of macroconidia, septation, size examined under a compound microscope.
Chlamydospores: For a better knowledge of the pathogen, investigations of occurrence and position of the Chlamydospores studied.
Pathogenic variability assessment of wilt pathogen
Pathogenicity assessment of the selected F. oxysporum f. sp. ciceri (FOC) isolates were done in a pot experiment on susceptible chickpea cultivar JG-62. Selected FOC isolates were mass multiplied separately by inoculation on soaked (overnight) and autoclaved sorghum seed. The soil taken for experiment was autoclaved for 3 days consequently at 15 lbs pressure for 30 minutes. The mass multiplied inoculum (sorghum seed) was mixed with the soil in 1:10 proportion, filled in the presterilized pots.
Seeds of susceptible chickpea cultivar JG-62, surface sterilized with the help of 1% NaOCl (Sodium hypochlorite solution) by putting them in it for 60 to 80 seconds (washed three to four time with distilled water) were seeded with maintaining five seed in each pot . Experiment was done with each isolate in replications. The virulence of the FOC was confirmed by appeared wilt symptoms and mortality of plants. Observations were noted after 30, 45, 60 days of sowing. The seedlings maintained in sterilized soil without inoculums were served as control.27
Results and discussion
Isolation, purification and maintenance of wilt pathogen
In the natural chickpea field the wilt disease was recognised on the basis of significant signs like yellowing of the leaves, withering and drying of the chickpea plants. When the roots of wilt-affected plants were split apart vertically, the xylem vessels were found brown in shade. Isolation and identification of wilt pathogen by diseased chickpea plant was done on PDA Petri plates by applying the tissue section method (Fig. 2). The isolated wilt pathogens were further purified by the single spore technique on PDA plates.24,25
Phenotypic variability of representative FOC isolates
In present study isolated FOC isolates were categorised in 4 categories on the basis of pigmentation, i.e. white violet, cottony white, white with ting of orange, pale yellow (Fig. 3).Total seventeen FOC isolates (Fusarium Oxysporum f. sp. ciceri) were selected as representative isolates. Representative FOC isolates were further sub-cultured and incubated at 26±1°C and studied for phenotypic (morphological and cultural) variability of wilt pathogens in study area.
![]() |
Figure 3: Phenotypic variability/ pigmentation of FOC isolates (A) White violet; (B) Cottony white; (C) White with ting of orange and (D) Pale yellow |
These representative FOC isolates exhibited great variations in colony characteristics i.e. margin, shape, texture of colony, spores (size and shape) etc. on PDA. Colony shape of FOC isolates was found irregular, circular or regular, whereas colony margins was entire or undulate whereas elevation of the colony was flat, partially raised and raised to on PDA medium. Colony textures were fluffy to flat/velvety (Table 1).
In present study, sporulation in all FOC isolates was abundant to moderate. In representative FOC isolates, micro-conidia were oval, cylindrical in shape with one or no septation and the minimum length ranges from 2.74-11.47 µm and maximum length was ranges from 10.00 – 26.81 µm and the minimum width ranges from 1.37 – 2.54 µm and maximum width was ranges from 3.42- 4.79 µm, whereas macro-conidia were curved, typically sickle shaped, ranged with 1-8 septa, the minimum length ranges from 12.59 – 29.11 µm and maximum length was ranges from 12.59 – 39.16 µm and the minimum width ranges from 2.14 – 3.8 µm and maximum width was ranges from 2.82 – 5.50 µm respectively. Chlamydospores were present (Fig. 4). The largest size of the micro-conidia was observed in UPFOC41 isolate (3.65 X 26.81, 1.47 × 3.60 μm) with 0-1 septation and the smallest size was observed from isolates UPFOC21 (4.29 X 10.00, 1.46 X 3.7 μm) with 0 septation. Whereas, the biggest size macro-conidia was observed in isolates UPFOC42 (18.54 X 39.16, 2.28 X 4.46) μm with 3-6 septation and the smallest size was observed in UPFOC33 ranged (12.59 X 12.59, 2.82 – 2.82μm) with 2-4 septation, However presence of Macroconidia in some isolates were rare or absent (Table 2).
Morphological characteristics of FOC earlier also studied by Singh and Gangwar (2017), they found mild, white, cottony culture, which becoming felted and wrinkled whereas mycelium was profusely bundled, hyaline, cylindrical, and septate, which produces white to light orange sporodochia covered with aerial mycelium on PDA. Colonies were originally, white shining in starting stage of growth, and whereas in advanced stages wine-red pigmentation of medium was observed, which was clearly visible from the reverse side of the plate. They observed microconidia were hyaline, single celled, oval to cylindrical, straight to slightly curve with 2.5 – 3.5 X 5 – 11 µm size. Though macroconidia were sparse and produced on branched macro conidiophores as well as fusoid with pointed ends, hyaline septate (3-4 septate) and 3.0-4.5 X 20-55 μm in size. Positions of chlamydospores were intercalary, globose to sub-globose, thick walled and smooth surfaced, swell form and formed singly or in pairs on the hyphae and found between 7.0 -8 X 3.5 – 5.0 μm size 1.
![]() |
Figure 4: A, B, C, D, E & F showing Microconidia and Macroconidia; G & H showing chlamydospores of FOC isolates. |
Cunnington (2007) earlier discovered that morphological characteristics can help to recognise the Fusarium Oxysporum species which include the shape of micro- and macroconidia, the arrangement of the micro conidiophore (false heads on short phialides generated on the hyphae), and the development of chlamydospores etc. They found macroconidia were typically 3-septate, small to medium in length, falcate to almost straight, and thin-walled however in other isolates, the apical cell is somewhat hooked and the basal cell is notched or foot shaped. On short monophialides microconidia grow in large quantities in the fake heads. They often lack septa and might be reniform, elliptical, or oval. They found that chlamydospores were made abundantly and within 2–4 weeks, however in some isolates the formation may be slow (4–6 weeks) or not at all. In some isolates chlamydospores are usually formed singly or in pairs, but may be found in clusters or small chains and position could be either terminal or intercalary, and although they can show up in submerged hyphae, they are most noticeable in hyphae on the agar surface. Colony morphology on Potato Dextrose Agar (PDA) varies greatly. While most isolates of Fusarium Oxysporum create a pale to dark violet or dark magenta pigment in the agar, some of them do not, at all. Mycelia can range in colour from white to pale violet and can be floccose, sparse, or profuse. In a core spore mass, certain isolates produce an abundance of pale orange or pale violet macroconidia. In some isolates, small, light brown, blue to blue-black, or violet sclerotia may be formed in large quantities. Some isolates have undergone mutations that result in the pionnotal form or a flat, “wet,” mycelial colony that appears yellow to orange on PDA 2.
Some other previous studies of Saxena et. al., 1987 and Chauhan, 1962 also witnessed colony culture with different type of pigmentations (yellow, brown, crimson) with relation to their mycelium type, colony colour, colony growth pattern, size of colony and pigmentations toxin production and pathogenicity variability was present.28,29 The length and breadth of micro conidia was found from 5.00-14.00 µm. and 1.00 – 4.00 µm respectively with 0 – 2 septa. Septation in macro conidia ranged from 1 – 5 with length 9.00 – 26.00 µm and 1.00 – 5.00 µm breadth.
Table 1: Morphological and cultural characteristics of representative FOC isolates
| FOC Code | Colour | Colony Shape | Colony Margin | Colony Elevation | Colony Texture | Sporulation | Microconidia | Macroconidia |
| UPFOC1 | White violet | Irregular | Entire | Partially Raised | Velvety | +++ | Present | Present |
| UPFOC6 | White violet | Irregular | Undulate | Flat | Fluffy | +++ | Present | Present |
| UPFOC12 | Cottony White | Regular | Undulate | Raised | Fluffy | ++ | Present | Present |
| UPFOC13 | Cottony White | Regular | Entire | Raised | Fluffy | ++ | Present | Present |
| UPFOC14 | Cottony White | Circular | Entire | Raised | Fluffy | ++ | Present | Present |
| UPFOC19 | White violet | Irregular | Undulate | Partially Raised | Velvety | +++ | Present | Present |
| UPFOC20 | White violet | Irregular | Undulate | Partially Raised | Fluffy | +++ | Present | Present |
| UPFOC21 | White violet | Irregular | Undulate | Partially Raised | Fluffy | +++ | Present | Absent |
| UPFOC31 | Cottony White | Regular | Entire | Raised | Fluffy | ++ | Present | Absent |
| UPFOC32 | Cottony White | Regular | Undulate | Raised | Fluffy | ++ | Present | Present |
| UPFOC33 | Cottony White | Regular | Entire | Raised | Fluffy | +++ | Present | Absent |
| UPFOC34 | Cottony White | Regular | Entire | Raised | Fluffy | ++ | Present | Present |
| UPFOC35 | White ting of orange | Regular | Entire | Raised | Fluffy | ++ | Present | Absent |
| UPFOC39 | Pale yellow | Circular | Undulate | Raised | Flat /Velvety | ++ | Present | Present |
| UPFOC41 | White ting of orange | Regular | Undulate | Raised | Velvety | ++ | Present | Present |
| UPFOC42 | Cottony White | Regular | Entire | Raised | Fluffy | ++ | Present | Present |
| UPFOC46 | Cottony White | Regular | Entire | Raised | Fluffy | +++ | Present | Absent |
![]() |
Table 2: Dimension and septation of representative FOC isolates |
*Based on 100 observation
Pathogenicity Test
Different strains of Fusarium Oxysporum are morphologically very much similar, so it is difficult to distinguish morphologically non-pathogenic or saprophytic strains from pathogenic ones. Isolates causing vascular disease are specific strains that infect only a specific host plant that are differentiated on the basis of pathogenicity as formae specials. Diagnosis as formae speciales is important and significant for isolation and analytical consequences of isolates. 5
FOC isolates were further tested for their pathogenicity on susceptible cultivar JG-62. Observations were recorded for appeared wilt symptoms on cultivar in 30, 45, 60 day intervals. On the basis of appeared wilt disease symptoms, virulence level was categorised in three different categories i.e., weakly pathogenic, moderately pathogenic, highly pathogenic.
In present study after 10-15 days of sowing, the first signs of wilt disease appeared in chickpea Plant in the form of drying of seedlings and thereafter at the adult stage (30 to 45 days) on the basis of appeared wilt symptoms like yellowing of the leaves, wilting and drying of plant (Fig. 5), the taproot and subordinate roots of the majority of plants turned dark brown, in comparison to control. In wilted plants, primarily damaged roots, which are delicate and prone to break, roots also have dark black streaks underneath their bark. Wilt pathogen blocked the xylem of the roots, which finally dried the entire plant.
![]() |
Figure 5: Pathogenicity assessment in FOC isolates |
In present study, ten FOC isolates i.e., UPFOC14, UPFOC31, UPFOC32, UPFOC33, UPFOC34, UPFOC35, UPFOC39, UPFOC41, UPFOC42,UPFOC46 were found moderately pathogenic (showed wilt symptoms like yellowing of leaves and wilting of plants) took 35 to 60 days to get infected and develop wilt symptoms, however only one FOC isolate i.e., UPFOC13 (isolated from Hastinapur, Jhansi district) was found weakly pathogenic or non-pathogenic (which has no symptoms to show).Total six FOC isolates i.e., UPFOC1, UPFOC6, UPFOC12, (isolated from Simardha and Hastinapur) and UPFOC19, UPFOC20, UPFOC21 (Babina village of Jhansi district) were found with medium to high pathogenicity, yellowing of leaves, wilting in plants and drying were appeared symptoms, they took 25 to 30 days to get infected and develop wilt symptoms out of seventeen representative UPFOC isolates (Table 3).
The Koch’s premise was validated when the fungus was re-isolated from the sick part and discovered to be identical to the original one.30 Pathogenicity tests showed the pathogenic abilities of FOC isolates.
Present findings of virulence assessment was supported by study of Benaouali et al., 2014 as they found only one seedling which had total death, while the others had stunted growth. The majority of plants developed dark brown taproots and secondary roots in addition to yellowing foliage. Seven isolates demonstrated moderate pathogenicity, five isolates were categorised as non-pathogenic looked like seedlings inoculated with distilled water.9
In another study, pathogenic ability of Fusarium Oxysporum f. sp. ciceri was tested on chickpea variety Radhey in pot culture. Findings of the study revealed that wilt symptoms appeared after 25 days of inoculation including with light yellow coloured leaves with drooping and then total wilting of the host plant. Findings of their experiment confirm that symptoms of artificially inoculated diseased plants were identical and confirmed, with naturally infected and wilted chickpea plants in the field. After 15 days of sowing, wilting with drying of seedling from the tip observed, total 20 plants take two months to get infected, whereas 14 plants wilted at adult stage. They observed that fine roots of the wilted plants were mainly affected in the xylem part of the plant and endured a dark black line below of their bark, becoming brittle and prone to break.1
Belabid et al. in 2004 also performed a pathogenicity test and found no link between the isolated geographic origin and their pathogenicity 31 as well as they observed various degrees of pathogenicity in populations of F. oxysporium f. sp. lentis.18,32–34
In a previous study Haware et al., 1992 and Nath et al., 2017 observed that infected seedlings downfall and lie on the soil surface and keep their dull green colour.23,35 Mature chickpea plants showed typical wilt symptoms such as sagging of petioles, rachis and leaflets. The roots of the wilted plants are unharmed externally, but internal xylem was rotted and dark brown discoloration was found. They confirmed that F. oxysporum f. sp. ciceri is disease causing and pathogenic to chickpea by above findings with pathogenic diversity among wilt isolates. Findings from Nene (1980) also support the present findings as they have done comprehensive studies of symptomatological signs of wilt at 3-5 weeks after sowing (seedling stage) and found different level of wilt incidence at 30 DAI and 60 DAI at 45 DAI whereas at 60 DAI, it fluctuated from medium to high level. Some isolates displayed a temporary reaction of variation in virulence.36
Table 3: Evaluation of pathogenicity of representative isolates by pathogenicity test
| S. No. | Categories | FOC Code |
| 1. | Weakly pathogenic/Non Pathogenic | UPFOC13, |
| 2. | Moderately Pathogenic | UPFOC14, UPFOC31, UPFOC32,UPFOC33, UPFOC34, UPFOC35,UPFOC39, UPFOC46,UPFOC41,UPFOC42 |
| 3. | Highly Pathogenic | UPFOC1, UPFOC6, UPFOC12, UPFOC19, UPFOC20, UPFOC21 |
The present study showed that Fusarium Oxysporum f. sp. ciceri has great variation in the isolated isolates of both districts of Bundelkhand region. Almost all fields of both districts have shown disease symptoms. The variation in disease incidence might be due to isolated variation in its pathogenicity or due to unfavourable environmental conditions.
Acknowledgement
The authors would like to thank Bundelkhand University, Jhansi for giving an opportunity to pursue Ph.D. research program and ICAR-IGFRI, Jhansi for providing all necessary facilities to carry out the work.
Conflict of Interest
The authors asserted no conflict of interest. This research received no external funding.
References
- Vikram DS, Gangwar RK. Symptomatology and pathogenicity characteristics of fusarium oxysporum f. Sp. ciceri in chickpea seeds. Int J Curr Res. 2017;9(6):52435-52437.
- Cunnington J, Lindbeck K, Jones RH. National Diagnostic Protocol for the detection of Fusarium Wilt of Chickpea (Fusarium oxysporum f. sp. ciceris). Published online 2007. https://www.planthealthaustralia.com.au/wp-content/uploads/2013/03/Fusarium-wilt-of-chickpea-DP-2007.pdf
- Yadav S, Yadav J, Singh SG. Performance of Azospirillum for improving growth, yield and yield attributing characters of maize (Zea mays. L) in presence of nitrogen fertilizer. Res J Agri Sci. 2011;2(1):139-141.
- Dubey SC, Suresh M. Randomly Amplified Polymeric DNA Markers for Trichoderma species and Antagonism against Fusarium oxysporum f. sp. ciceris causing Chickpea Wilt. J Phytopathol. 2006;154:663-669.
- Leslie JF, Summerell BA. Species Concepts in Fusarium.; 2006.
- Navas-Cortes JA, Hau B, Jimenez-Diaz RM. Yield loss in chickpea in relation to development of Fusarium wilt epidemics. Phytopathology. 2000;90:1269-1278.
- Jalali BL, Chand H. Plant Diseases of International Importance . Dis Cereal Pulses. 1992;1.
- Nene YL, Sheila VK, Sharma SB. A World List of Chickpea and Pigeon Pea Pathogens.; 1996.
- Benaouali H, Hamini-Kadar N, Bouras A, Benichou SL, Kihal M, Henni JE. Isolation, pathogenicity test and physicochemical studies of Fusarium oxysporum f.sp radicis lycopersici. Adv Environ Biol. 2014;8(10):36-49.
- Kowalski CH, Cramer RA. If looks could kill: Fungal macroscopic morphology and virulence. Jabra-Rizk MA, ed. PLOS Pathog. 2020;16(6):e1008612. doi:10.1371/journal.ppat.1008612
- Toledo-Souza ED, Silveira PM, Café-Filho AC, Lobo Junior M. Fusarium wilt incidence and common bean yield according to the preceding crop and the soil tillage system. Pesq Agropec, Bras. 2012;47:1031-1037.
- Mutitu EW. Fusarium Yellows of Beans Caused by Fusarium Oxyposrum f. Sp. Phaseoli in Kenya. University of Nairobi; 1988.
- Dubey S, Singh B. Reaction of chickpea genotypes against Fusarium oxysporum f. sp. ciceri causing vascular wilt. Ind Phytopathol. 2004;57:233.
- Trapero-Casas A, Jimenez-Diaz RM. Fungal wilt and root rot diseases of chickpea in southern Spain. Phytopathology. 1985;75:1146–1151.
- Gerhardson B. Biological substitutes for pesticides. Trends Biotechnol. 2002;20:338-343.
- Gowda SJM, Radhika P, Kadoo NY, Mhase LB, Gupta VS. Molecular mapping of wilt resistance genes in chickpea. Mol Breed. 2009;24(2):177-183. doi:10.1007/s11032-009-9282-y
- Pathak PS, Singh JP, Sharma P, Singh KK, Dwivedi PN, Singh JB. Bundelkhand Region: Agricultural Perspectives (Status, Constraints and Prospects).; 2005.
- Haware MP, Nene YL. Races of Fusarium oxysporum f.sp. ciceri. Plant Dis. 1982;66:809-810.
- Haware MP, Nene YL, Natarajan M. Survival of Fusarium oxysporum f sp ciceri in soil absence of chickpea. Phytopathol Mediterr. 1996;35:9– 12.
- Golakiya BB, Bhimani MD, Akbari LF. Characterization of Indian Isolates of Fusarium oxysporum f. sp. ciceri Causing Chickpea Wilt. Int J Curr Microbiol Appl Sci. 2018;7(03):1152-1162. doi:10.20546/ijcmas.2018.703.137
- Nene YL, Haware MP, Reddy M V. Chickpea Diseases: Resistance Screening Techniques. Int. Crop Res.; 1981.
- Singh KB, Reddy M V. Advances in disease resistance breeding in chickpea. Adv Agron. 1991;45:191–222.
- Nath N, Ahmed AU, Aminuzzaman FM. Morphological and physiological variation of Fusarium oxysporum f. sp. ciceri isolates causing wilt disease in chickpea. Int J Environ Agric Biotechnol. 2017;2(1):202-212. doi:10.22161/ijeab/2.1.25
- Abou-Zeid NM, Halila H, Khalil MS. Characterization by RAPD-PCR of races of Fusarium oxysporum f. sp. ciceri infecting chickpea. In: Proceedings of the 6th Conference of European Foundation for Plant Pathology: Disease Resistance in Plant Pathology. Plant Protection Science; 2002:297-301.
- Aneja KR. Experiments in Microbiology, Plant Pathology and Biotechnology . 4th Edn. New Age International Pvt. Ltd., India.; 2005.
- Booth C. The Genus Fusarium.; 1971.
- Dubey SC, Singh SR, Singh B. Morphological and pathogenic variability of Indian isolates of Fusarium oxysporum f. sp. ciceris causing chickpea wilt. Arch Phytopathol Plant Prot. 2010;43(2):174-190. doi:10.1080/03235400802021108
- Saxena, M. C. and Singh KB. The chickpea. CAB Int ICARDA. Published online 1987:250-252.
- Chauhan SK. Physiologic variation in F. orthoceras App. Wr. Var. ciceris causing wilt of gram. In: Natn. Acad. Sci. Sec. B. ; 1962:78-84.
- Koch R. Liber Die Milzbrand Imp. Fungus, Lime, Emtgegnung Auf. Den. von. Pasteur in Genf. Gehatene Vortrag. T. Fischer. Kassel.; 1882.
- Belabid L, Baum M, Fortes Z, Bouznad Z, Eujayl I. Pathogenic and genetic characterization of Algerian isolates of Fusarium oxysporum f. sp. lentis by RAPD and AFLP analysis. Afr J Biotechnol. 2004;3:25-31.
- Gupta O, Khare MN, Kotasthane SR. Variability among six isolates of Fusarium oxysporum f.sp. ciceri causing vascular wilt of chickpea. Indian Phytopathol. 1986;39(2):279–281.
- Honnareddy N, Dubey SC. Pathogenic and molecular characterization of Indian isolates of Fusarium oxysporum f.sp. ciceris causing chickpea wilt. Curr Sci. 2006;91:661-666.
- Rahman ML, Haware MP, Mian IH, Akananda AM. Races of Fusarium oxysporum f.sp. ciceri causing chickpea wilt in India. Bangladesh J Plant Pathol. 1998;14:234-237.
- Halila MH, Strange RN. Screening of Kabuli chickpea germplasm for resistance to Fusarium wilt. Euphytica. 1997;96(2):273-279. doi:10.1023/A:1003051100683
- Nene YL, Haware MP. Screening chickpea for resistance to wilt. Pl Dis. 1980;64:379–380.